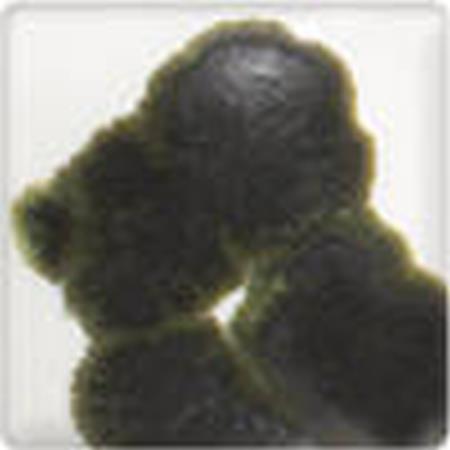
Pewter Crystals

1
/
of
1
Brand: Spectrum Glazes
Pewter Crystals
Pewter Crystals
Regular price
£3.35
Regular price
Sale price
£3.35
Unit price
/
per
Delivery from £2.95, free over £30
In stock
Couldn't load pickup availability
These resemble small, dry coloured rocks that can be mixed with either clear glaze, glaze, or underglaze. The crystals will melt and flow during firing to achieve a wide variet of colour combinations and results. CLSPCR100 MPN SPCR100